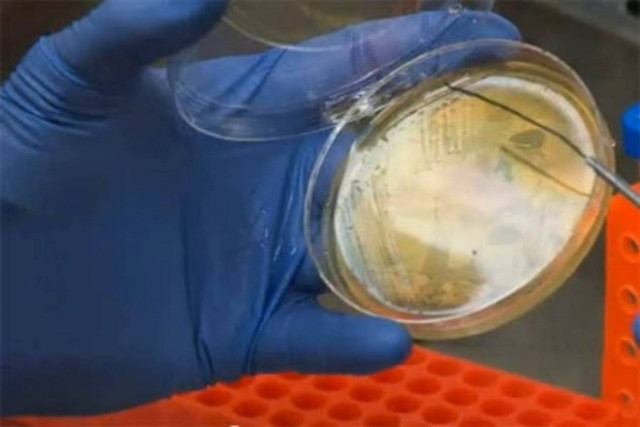
Συναγερμός στην Κούβα με νέα επιδημία

ΑΒΑΝΑ

Η Κούβα... πλούτισε χάρη σε υγραντήρες πούρων
ΚΟΣΜΟΣ
·
01.03.2014 - 23:38
Σημαντικά έσοδα που θα χρησιμοποιηθούν προς όφελος του συστήματος υγείας, εξασφάλισε η κουβανική κυβέρνηση, χάρη σε μια απλή δημοπρασία υγραντήρων πούρων.

Κούβα: Οι οδηγοί ταξί θα εργάζονται σαν ιδιώτες
ΚΟΣΜΟΣ
·
09.01.2014 - 01:11
Οι αρχές της Κούβας θα επιτρέψουν στους οδηγούς ταξί που έως σήμερα δραστηριοποιούνται στις κρατικές εταιρείες και υπηρεσίες να εργάζονται πλέον σε όλο το νησί…

Η ΓΣ του ΟΗΕ ψήφισε για 22η φορά κατά του εμπάργκο της Αβάνας
ΚΟΣΜΟΣ
·
29.10.2013 - 22:08
Η Γενική Συνέλευση του ΟΗΕ ενέκρινε με μεγάλη πλειοψηφία σήμερα για 22η φορά μια απόφαση με την οποία καταδικάζει το εμπάργκο που επιβάλλουν οι Ηνωμένες…

Μόσχα: Θρίλερ με τον Σνόουντεν-Διαψεύδει ο Λαβρόφ
ΚΟΣΜΟΣ
·
25.06.2013 - 13:12
Ο καταζητούμενος από τις αμερικανικές αρχές Έντουαρντ Σνόουντεν φέρεται να έφθασε στη Μόσχα την Κυριακή προερχόμενος από το Χονγκ Κονγκ, με εισιτήριο για χθεσινή πτήση…

Έντουαρντ Σνόουντεν: Κανένα ίχνος του στην Αβάνα
ΚΟΣΜΟΣ
·
25.06.2013 - 08:41
Κανένα ίχνος του Έντουαρντ Σνόουντεν δεν κατάφεραν να εντοπίσουν οι δημοσιογράφοι που παρακολουθούσαν στενά το αεροσκάφος της ρωσικής αεροπορικής εταιρείας Aeroflot, το οποίο προσγειώθηκε χθες…

Από την Κούβα στις ΗΠΑ χωρίς προστατευτικό κλουβί για τους καρχαρίες
ΚΟΣΜΟΣ
·
12.06.2013 - 08:29
Η Αυστραλή κολυμβήτρια Χλόε Μακάρντελ θα αψηφήσει τους καρχαρίες και θα επιχειρήσει να κολυμπήσει χωρίς προστατευτικό κλουβί τα 103 μίλια (166 χιλιόμετρα) μεταξύ της Κούβας…

Αβάνα: Η κόρη του Κάστρο υπέρ των ομοφυλόφιλων
ΚΟΣΜΟΣ
·
12.05.2013 - 14:58
Εκατοντάδες Κουβανοί πήραν μέρος σε διαδήλωση στην Αβάνα για την προστασία των δικαιωμάτων των ομοφυλόφιλων.

Στους δρόμους της Αβάνας με τύμπανα και τρομπέτες οι ομοφυλόφιλοι
ΚΟΣΜΟΣ
·
12.05.2013 - 08:28
Περίπου 500 Κουβανοί διαδήλωσαν στους δρόμους της Αβάνας, στο πλαίσιο κινητοποίησης υπέρ των δικαιωμάτων των ομοφυλοφίλων και κατά της ομοφοβίας.

Επίσημη επίσκεψη στην Κούβα για τον Μεντμέντεβ
ΚΟΣΜΟΣ
·
22.02.2013 - 03:11
Ο πρωθυπουργός της Ρωσίας, Ντμίτρι Μεντβέντεφ έφθασε στην Κούβα, όπου θα συναντηθεί με τον πρόεδρο της χώρας, Ραούλ Κάστρο και θα υπογράψει διάφορες συμφωνίες στους…

Βίντεο: Ο Γάλλος «Spiderman» σε ξενοδοχείο της Αβάνας
ΚΟΣΜΟΣ
·
05.02.2013 - 09:36
Το ξενοδοχείο «Havana Libre», ένα από τα σύμβολα της κουβανικής πρωτεύουσας, επέλεξε ο Αλέν Ρομπέρ ή Γάλλος «Spiderman» για να κατακτήσει την κορυφή του.
Συναγερμός στην Κούβα με νέα επιδημία
ΚΟΣΜΟΣ
·
15.01.2013 - 23:34
Η κυβέρνηση της Κούβας επιβεβαίωσε σήμερα το ξέσπασμα επιδημίας χολέρας στη χώρα, αναφέροντας ότι ήδη 51 άνθρωποι έχουν νοσήσει.

Κρίσιμες ώρες για τον Ούγκο Τσάβες - Nέα επιδείνωση της υγείας του
ΚΟΣΜΟΣ
·
04.01.2013 - 06:20
Επιδείνωση έχει παρουσιάσει η κατάσταση του Ούγκο Τσάβες, καθώς ο πρόεδρος της Βενεζουέλας υποφέρει από λοίμωξη του αναπνευστικού, γεγονός που επιφέρει περαιτέρω επιπλοκές στην υγεία…

Σταθερή η κατάσταση του Ούγκο Τσάβες
ΚΟΣΜΟΣ
·
13.12.2012 - 07:17
Σταθερή είναι η κατάσταση της υγείας του Ούγκο Τσάβες, μετά την πολύωρη εγχείριση στην οποία υποβλήθηκε σε νοσοκομείο της Αβάνας στην Κούβα.

Αναχώρησε για την Κούβα ο Τσάβες
ΚΟΣΜΟΣ
·
10.12.2012 - 13:59
Για την Αβάνα αναχώρησε ο πρόεδρος της Βενεζουέλας Ούγκο Τσάβες, σήμερα το πρωί, όπου θα υποβληθεί σε νέα επέμβαση για μετά την επανεμφάνιση του καρκίνου,…

Παράνομο «στα χαρτιά» το αμερικανικό εμπάργκο στην Κούβα
ΚΟΣΜΟΣ
·
13.11.2012 - 21:59
Για πολλοστή φορά, η Γενική Συνέλευση του ΟΗΕ κάλεσε σήμερα τις ΗΠΑ να άρουν το οικονομικό εμπάργκο που έχουν επιβάλλει στην Κούβα από τη δεκαετία…

Κούβα: Μέτρα για τον επαναπατρισμό γιατρών και αθλητών
ΚΟΣΜΟΣ
·
25.10.2012 - 09:03
Η Αβάνα ανακοίνωσε ευνοϊκά μέτρα για τον επαναπατρισμό μεταναστών, κυρίως γιατρών ή αθλητών, που βγήκαν παράνομα από την Κούβα ή εγκατέλειψαν τις αποστολές τους κατά…

Πάμε Κούβα;
ΤΑΣΟΣ ΘΕΟΔΩΡΟΠΟΥΛΟΣ
·
17.08.2012 - 16:28
Ο Τάσος Θεοδωρόπουλος ανάβει πούρο7 ΗΜΕΡΕΣ ΣΤΗΝ ΑΒΑΝΑ / 7 DIAS EN LA HABANAΒαθμολογία: 6 / 10

Ο Τσάβες ολοκλήρωσε με επιτυχία τη θεραπεία του στην Κούβα
ΚΟΣΜΟΣ
·
12.05.2012 - 07:21
«Το τέλος και την επιτυχία» της θεραπείας κατά του καρκίνου, στην οποία υποβαλλόταν, ανακοίνωσε ο πρόεδρος της Βενεζουέλας, Ούγκο Τσάβες, κατά την επιστροφή στο Καράκας…

Βίντεο: Τα δάκρυα και η προσευχή του Τσάβες στο Θεό
WHAT THE FACT
·
07.04.2012 - 21:19
Ο Ούγκο Τσάβες με δακρυσμένα μάτια προσεύχεται να του «δώσει ζωή» ο Θεός.

Ο Φιντέλ θα συναντήσει τον Πάπα
ΚΟΣΜΟΣ
·
28.03.2012 - 09:14
«Ευχαρίστως» θα συναντήσει τον Πάπα Βενέδικτο ο Φιντέλ Κάστρο, την τελευταία ημέρα της τριήμερης επίσκεψής του στην Κούβα, όπως ανακοίνωσε σε ανοιχτή επιστολή του.

Στην Αβάνα η συνάντηση Πάπα- Ραούλ Κάστρο
ΚΟΣΜΟΣ
·
27.03.2012 - 21:23
Ο Πάπας Βενέδικτος ΙΣΤ βρίσκεται ήδη στην Αβάνα.

Ξανά στην Αβάνα για θεραπεία ο Τσάβες
ΚΟΣΜΟΣ
·
25.03.2012 - 08:21
Για την Αβάνα αναχώρησε ο Ούγκο Τσάβες το βράδυ του Σαββάτου, για να υποβληθεί σε ακτινοθεραπεία.

Συνάντηση Κάστρο με Τσάβεζ
ΚΟΣΜΟΣ
·
03.03.2012 - 07:24
Φωτογραφίες του προέδρου της Βενεζουέλας, Ούγκο Τσάβες με τον πρώην ηγέτη της Κούβας, Φιντέλ Κάστρο, δημοσίευσε στο twitter του ο υπουργός Πληροφόρησης της Βενεζουέλας Άντρες…

Επιταχύνεται η ανάρρωση του προέδρου Τσάβες
ΚΟΣΜΟΣ
·
01.03.2012 - 21:29
«Είμαι πολύ καλά» δήλωσε ο πρόεδρος της Βενεζουέλας, Ούγκο Τσάβες, μιλώντας τηλεφωνικά στη δημόσια τηλεόραση της χώρας από την Αβάνα, όπου νοσηλεύεται.







